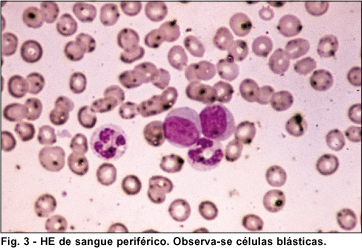

Ciro Massaiuki Komagome1; Luciene Barbosa de Sousa2; Maria do Carmo Pinheiro3; Moacyr Rigueiro4; Isabel Cristina Proença Gil5; Denise de Freitas6
DOI: 10.1590/S0004-27492000000100015
RESUMO
Os autores descrevem o caso de paciente portadora de leucemia mielóide aguda que apresentou como primeira manifestação da doença, infiltração leucêmica conjuntival. São feitas considerações a respeito das manifestações sistêmicas e oftalmológicas e atualização desta doença.
Descritores: Leucemia mielóide; Infiltração; Conjuntiva; Cloroma; Sarcoma granulocítico
ABSTRACT
The authors present a case of acute myelogenous leukemia whose first symptom was infiltration of the conjunctiva. The clinical and ophthalmologic characteristics are discussed and reviewed.
Keywords: Leukemia, myelocytic; Conjunctiva; Chloroma; Granulocytic sarcoma
INTRODUÇÃO
As leucemias são neoplasias derivadas de células hematopoéticas, que proliferam a princípio na medula óssea, antes de se disseminar para o sangue periférico, baço, linfonodos e por fim, outros tecidos 1.
A classificação das leucemias baseia-se, em grande parte, na célula de origem (linfóide ou mielóide), bem como na velocidade de seu curso clínico (aguda ou crônica). A leucemia aguda caracteriza-se pela proliferação clonal de células hemapoéticas imaturas. De acordo com a linhagem, pode ser dividida em leucemia mielóide aguda (mieloblastos ou promielócitos) ou leucemia linfocítica aguda (linfoblastos) 1.
As manifestações clínicas da leucemia mielóide aguda se caracterizam por quadro de anemia, palidez, fatigabilidade fácil e dispnéia aos pequenos esforços. O sangramento está relacionado ao quadro de trombocitopenia, podendo estar associado com aparecimento de petéquias e equimoses. A infecção é uma complicação praticamente universal da leucemia aguda e é inversamente proporcional ao número de neutrófilos circulantes 1.
Pode-se verificar o desenvolvimento de massas de células leucêmicas em tecidos moles em qualquer localização, sendo que algumas vezes a leucemia extramedular com acometimento ocular pode preceder o comprometimento detectável da medula óssea 3.
O acometimento de tecidos oculares é raro tendo a retina e coróide como sítios mais comuns. Alterações retinianas ocorrem em 30% a 90% dos casos de leucemia 3, 4. Dilatações e aumento de tortuosidade dos vasos e hemorragias retinianas são os achados mais comuns. Porém, pode-se observar exsudatos algodonosos e manchas acinzentadas indicando infiltração leucêmica 3.
A coróide é um dos tecidos oculares mais envolvidos por infiltração leucêmica em estudos histopatológicos, variando de 65% a 85%. Os achados mais comuns são aumento da espessura, hiperplasia e hipertrofia dos tecidos uveais 3.
A infiltração leucêmica da íris e segmento anterior do olho é mais rara, porém já foram descritos casos que simulavam quadros de uveítes, com formação de pseudohipópio provenientes das células tumorais 6 . Outros achados que podem ser observados são heterocromia de íris e glaucoma agudo 3, 10.
A órbita pode estar envolvida em cerca de 8% dos casos de leucemia mielóide aguda, mais comumente em quadros agudos. O quadro clínico característico é de proptose, edema palpebral e quemose 5, 7. Massa orbital de células da linhagem mieloblástica eram conhecidas como cloromas ou sarcomas granulocíticos devido à coloração esverdeada decorrente da reação da enzima mieloperoxidase 5.
Acometimento da córnea é muito raro devido à característica avascular do tecido corneano 3.
O objetivo do trabalho é apresentar e discutir as manifestações clínicas num caso raro de infiltração leucêmica em conjuntiva.
RELATO DO CASO
E.B.S., 20 anos, do sexo feminino, natural de Goiás e procedente de São Paulo há 10 anos. Procurou nosso serviço, com queixa de olhos inchados e saída de secreção há 4 meses. Procurou outros serviços de oftalmologia tendo sido tratada com colírio de ciprofloxacina associado a dexametasona, três vezes ao dia por três semanas, sem melhora do quadro. Referia febre diária, adinamia e perda ponderal de 7 Kg, nesse período. Há 1 mês referia epistaxe e hematomas espontâneos.
No exame físico geral apresentava-se em regular estado geral e descorada ++.
À palpação, o fígado apresentava-se a 2 cm do rebordo costal direito.
Ao exame oftalmológico, apresentava acuidade visual sem correção de 0,5 no olho direito e 0,4 no olho esquerdo.
À ectoscopia, apresentava em ambos os olhos edema palpebral +++, hiperemia +++ e quemose conjuntival.
Ao exame biomicroscópico do segmento anterior, observava-se em ambos, os olhos a presença de hiperemia e quemose conjuntival, micropapilas e folículos esparsos na conjuntiva tarsal, úlceras conjuntivais recobertas por material fibrinóide e cicatrizes adjacentes associadas à saída de secreção mucóide esbranquiçada e membranas (Figura 1). Na córnea observava-se ceratite punctata em ambos os olhos.

A medida da pressão ocular era 12 mmHg em ambos os olhos, motilidade ocular extrínseca e fundoscopia não apresentando alterações.
Para esclarecimento diagnóstico, foram solicitados os seguintes exames: hemograma, VDRL, FTA-Abs, PPD, urina I, Rx de tórax e de seios da face, provas reumatológicas (VHS, FAN, p-ANCA, células LE), colheita de material da conjuntiva tarsal para citologia e cultura e biópsia incisional das lesões conjuntivais.
Após 05 dias de evolução, a paciente retornou com quadro inalterado. Os resultados dos exames foram todos normais, com exceção do hemograma que revelou anemia, plaquetopenia e leucocitose (blastos 35%). O exame anátomo-patológico da lesão conjuntival revelou presença de infiltrado difuso do córion por células atípicas de citoplasma eosinofílico e granuloso, com presença de figuras de mitose sugestivas de origem mielóide granulocítica (Figura 2). O exame imuno-histoquímico pelo método da strepto-avidina-biotina-complexo peroxidase mostrou positividade para antígeno leucocitário comum e lisozima.

Frente ao quadro, a paciente foi internada e submetida à tomografia computadorizada de crânio e órbita. Repetição do hemograma mostrou 7,0g/dl hemoglobina, hematócrito de 21%, 113000/mm3 plaquetas, 9700 mm3 (1-38-2-0-13-0) glóbulos brancos e presença de 46% de células blásticas (Figura 3).
O mielograma com imunofenotipagem revelou presença de medula óssea hipercelular, com 44,5% de blastos mielóides (com bastonetes de Auer) e marcadores mielóides positivos e linfóides negativos. Foi feito o diagnóstico de leucemia mielóide aguda, subtipo M2 (mieloblástica aguda com diferenciação) (Figura 4).

A paciente foi submetida a tratamento quimioterápico com daunorubicina e cytarabina levando a regressão progressiva do quadro ocular, posteriormente submetida ao transplante de medula óssea.
DISCUSSÃO
A leucemia envolvendo os tecidos oculares é rara, embora possa ser a primeira manifestação extramedular da doença e simular diversas outras alterações oculares 1.
A infiltração leucêmica conjuntival como primeira e única manifestação de um quadro de leucemia mielóide aguda foi descrita apenas uma vez na literatura médica 2. Geralmente envolve os tecidos oculares mais tardiamente sendo a retina, órbita, nervo óptico e trato uveal os locais mais acometidos 3-5.
O envolvimento conjuntival é mais freqüente nos pacientes com leucemias linfocíticas. Em estudo retrospectivo, foi encontrado 4% (14/384) de algum grau de infiltração leucêmica, porém nenhum dos casos revistos eram de leucemias de linhagem mieloblástica como o caso descrito 2, 3, 8.
Em nosso caso, o diagnóstico foi confirmado pela biópsia conjuntival, porém este método mostrou baixa positividade nos trabalhos em que havia suspeita de infiltração leucêmica da conjuntiva.
A paciente apresentava um quadro de leucemia mielóide aguda subtipo M2 (LMA-M2). O prognóstico é satisfatório em adultos jovens, quando associado à hepatoesplenomegalia e infiltração de tecidos moles, geralmente relacionado às alterações cromossômicas, no caso translocação t(8,21) 1.
No caso relatado, o acometimento foi extraocular com infiltração da conjuntiva tarsal, confirmada pela biópsia incisional. A paciente não apresentava alterações tomográficas, restringindo-se a infiltração apenas ao tecido conjuntival.
Por fim, ressalta-se a importância de se realizar uma propedêutica geral e bem direcionada em casos de alterações oculares atípicas, que podem ser a primeira manifestação de doenças sistêmicas graves.
REFERÊNCIAS BIBLIOGRÁFICAS
1. Scheinberg DA, Golde DW. The leukemias, Harrison's. Principles of Internal Medicine, 13th ed, McGraw-Hill, 1994, cap 310.
2. Lee DA, Su WPD. Acute myelomonocytic leukemia cutis presenting as a conjunctival lesion. Internat J Dermatology 1985;24:369.
3. Kincaid MC, Green WR. Ocular and orbital involvement in leukemia. Surv Ophthalmol 1983;27(4):211.
4. Karesh JW, Goldman EJ, Reck K, Kelman SE, Lee EJ, Schiffer CA. A prospective ophthalmic evaluation of patients with acute myeloid leukemia: correlation of ocular and hematologic findings. J Clin Oncol 1989;7(10):1528.
5. Zimmerman LE, Font RL. Ophthalmologic manifestations of granulocytic sarcoma. Am J Ophthalmol 1975;80(6):975.
6. Ayliffe W, Foster CS, Marcoux P, Upton M, Legmann A. Relapsing acute myeloid leukemia manifesting as hypopyon uveitis. Am J Ophthalmol 1995;119(3):361.
7. Ford JG, Yeatts RP, Hartz JW, Chauvenet A. Granulocytic sarcoma of the eyelid as a presenting sign of leukemia. J Ped Ophthalmol Strabismus 1993;30:386.
8. Mansour AM, Traboulsi EI, Frangieh GT, Jarudi N. Caruncular involvement in myelomonocytic leukemia: a case report. Med Ped Oncol 1985;13:46.
9. Curto ML, Zingone A, Acquaviva A, Bagnulo S, Zanesco L. Med Ped Oncol 1989;17:134.
10. Katz SE, Wade K, Anderson DP, Rootman J. Anterior segment recurrence of acute myelogenous leukemia: treatment with subconjuntival injections of methotrexate and triancinolone acetonide. Can J Ophthalmol 1997;32(4):265.
(1) Residente do Terceiro ano do Departamento de Oftalmologia da EPM-UNIFESP
(2) Doutora em Oftalmologia do Setor de Doenças Externas do Departamento de Oftalmologia da EPM-UNIFESP
(3) Médica voluntária do Departamento de Oftalmologia da EPM-UNIFESP
(4) Professor Assistente do Departamento de Anatomia Patológica da EPM-UNIFESP
(5) Pós-graduanda da Disciplina de Hematologia do Departamento de Clínica Médica da EPM-UNIFESP
(6) Doutora em Oftalmologia e Chefe do Setor de Doenças Externas do Departamento de Oftalmologia da EPM-UNIFESP.
Endereço para correspondência: Ciro Massaiuki Komagome. Universidade Federal de São Paulo ¾ UNIFESP. Departamento de Oftalmologia. Rua Botucatu, 820, São Paulo (SP) CEP 04023-062. email: [email protected]